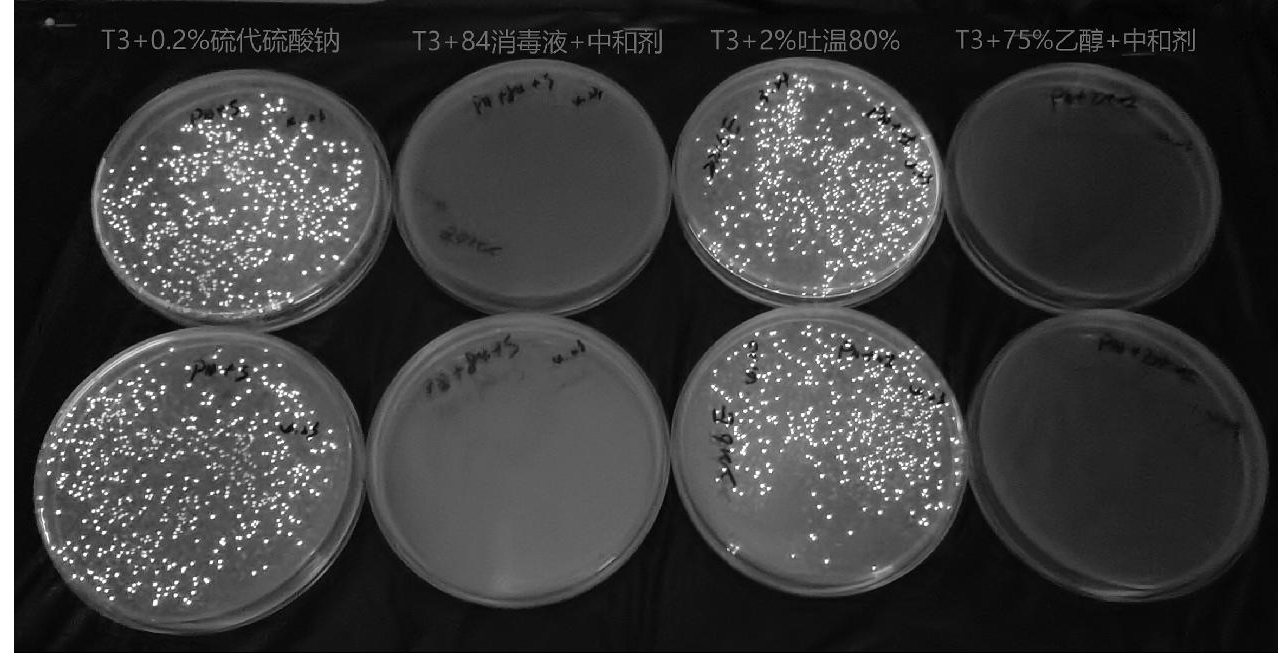

CopyRight 2009-2020 © All Rights Reserved.版权所有: 中国海关未经授权禁止复制或建立镜像
发光细菌快速评价消毒处理效果技术研究
作者:黄迎波 袁小雅 王哲 周慧平 彭梓 莫瑾
黄迎波 袁小雅 王哲 周慧平 彭梓 莫瑾
黄迎波 1 袁小雅 1 王 哲 1 周慧平 1 彭 梓 1 莫 瑾 1 *
摘 要 本研究基于发光细菌的发光原理,以明亮发光杆菌(Photobacterium phosphoreum)T3变种和费氏弧菌(Vibrio fischeri)作为特定性微生物评价常见消毒剂喷雾消毒处理效果,分析其发光条件、中和剂等,进而建立一种发光细菌法快速评价现场消毒效果的方法。结果表明,84消毒液、75%乙醇等常用喷雾消毒剂均可抑制明亮发光杆菌和费氏弧菌的生长,明亮发光杆菌可通过涂抹法测定相对发光强度,有效评价喷雾消毒效果,与目前消毒效果评价指示菌株金黄色葡萄球菌、大肠埃希氏菌等评价结果基本一致。该方法能客观、快速、准确地评价喷雾消毒效果,可解决当前消毒处理效果评价中操作繁琐、耗时较长的问题,在口岸卫生检疫和动植物疫情等防控领域中具有广泛的应用前景。
关键词 发光细菌;喷雾消毒;发光强度;效果评价
The Rapid Evaluation Technology for Disinfection and P est C ontrol T reatment E ffect by L uminescent B acteria
H UANG Ying -B o 1 YUAN Xiao-Ya 1 W ANG Zhe 1 Z HOU Hui -P ing 1 P ENG Zi 1 MO Jin 1*
Abstract Based on the principle of luminescence of luminescent bacteria, and using Photobacterium phosphoreum T3 and Vibrio fischeri as specific microorganisms, study its luminous condition, neutralizer and so on, establish a rapid evaluation method for on-site disinfection effect by luminescent bacteria. The results demonstrated that commonly used spray disinfectants, including 84 disinfectant and ethanol, effectively inhibited the growth of Photobacterium phosphoreum and Vibrio fischeri. The relative luminous intensity measured by the smearing method provided an effective means of evaluating spray disinfection, yielding results consistent with those obtained using conventional indicator strains such as Staphylococcus aureus and Escherichia coli. This method enables objective, rapid, and accurate detection of disinfection effectiveness, while overcoming the limitations of existing evaluation methods, which are often cumbersome and time-consuming. It holds broad application prospects in port health quarantine and in the prevention of animal and plant epidemics.
Keywords luminescent bacteria; spray disinfection; luminous intensity; effect evaluation
预防性消毒和卫生处理等是海关在疫情防控中的常用措施,为确保达到消毒效果,对消毒效果进行评价是其中的一个重要环节。目前,我国国家标准中喷雾消毒效果评价采用的生物指示菌株为金黄色葡萄球菌、大肠埃希氏菌、铜绿假单胞菌等致病性微生物,都需要培养48 h后进行评判,耗时较长、操作较繁琐[1]。发光细菌是一类非致病性的革兰氏阴性兼厌氧细菌,在正常的培养条件下能够发射波长在450~490 nm的可见荧光,在黑暗处肉眼可见[2]。由于其独特的生物发光特性,在水质毒性、环境毒性监测中有着广泛的应用。本研究根据发光细菌对消毒因子的敏感性和自发荧光可快速测试的生理特性,将其作为指示菌株来评价各类消毒剂的除害处理和消毒效果,替代传统的致病性指示菌株,实现对消毒场所现场快速、准确评价消毒效果的目标。
1 材料与方法
1.1 材料
1.1.1 仪器
微孔板生物发光光度计(Spark 10M,瑞士TECAN公司);恒温培养箱(IPP260,美国美墨尔特公司);A2型生物安全柜(HFsafe1200LC,上海力申公司);冻干机(FreeZone 6Plus,美国Labconco公司)等。
1.1.2 试剂
84消毒液(晋州腾胜日化公司);75%乙醇(安徽安特食品公司);无水磷酸氢二钠、磷酸二氢钾、磷酸氢二钾、七水硫酸镁、磷酸氢二氨、胰蛋白胨、酵母粉、氯化钠、硫代硫酸钠、吐温80、甘油等均采购于国药集团化学试剂有限公司。
1.1.3 菌株
明亮发光杆菌(Photobacterium phosphoreum)T3变种、费氏弧菌(Vibrio fischeri)采购于上海谷研实业有限公司;金黄色葡萄球菌(Staphylococcus aureus)ATCC 6538、大肠埃希氏菌(Escherichia coli)ATCC 25922、水稻细菌性条斑病菌(Xanthomonas oryzae pv.oryzicola)NCPPB 1511为长沙海关技术中心保存菌株。
1.1.4 培养基
2216E琼脂培养基、2216E液体培养基、发光菌培养基、胰蛋白胨大豆琼脂培养基(Tryptose Soya Agar,TSA);胰蛋白胨大豆肉汤培养基(Tryptose Soya Broth,TSB);3%牛血清白蛋白贮存溶液(Bovine Serum Albumin Solution,BSA);营养琼脂培养基(Nutrient Agar,NA);营养肉汤培养基(Nutrient Broth,NB);0.03 mol/L磷酸盐缓冲液(Phosphate Buffered Saline,PBS)等。
1.2 方法
1.2.1 发光细菌培养基选择
由于明亮发光杆菌和费氏弧菌均为海洋发光菌,故采用已商品化的海生细菌增菌培养基2216E培养基、发光菌分离培养基和文献方法培养基配方作为本研究的筛选培养基,其中明亮发光杆菌文献方法培养基配方为胰蛋白胨5.0 g、酵母粉5.0 g、Na2HPO4 5.0 g、KH2PO4 1.0 g、NaCl 30.0 g、甘油3.0 g,去离子水溶解定容至1000 mL,调节pH至7.0[3];费氏弧菌文献方法培养基配方为胰蛋白胨 5.0 g、酵母粉0.5 g、Na2 HPO4 6.1 g、K2HPO4 2.75 g、MgSO4·7H2O 0.204 g、(NH4)2HPO4 0.5 g、NaCl 30.0 g、甘油3.0 g[4-5]。接种发光菌置3种液体培养基中,在18℃静置黑暗培养条件下测量发光强度,确定最佳发光培养基配方。
1.2.2 发光细菌培养条件优化
(1)接种量。分别接种1%、2%、3%、4%、5%的明亮发光杆菌和费氏弧菌新鲜菌液(浓度约为108 CFU/mL)于2216E液体培养基中,在18℃静置培养条件下培养24 h,测定发光强度,重复3次试验取中间值,确定最佳接种量。
(2)培养温度。采用最佳培养基和接种量,将菌液分别在15℃、18℃、20℃、22℃、25℃下静置培养24 h,测定发光强度,重复3次试验取中间值,确定最佳培养温度。
1.2.3 中和剂的筛选
(1)中和剂的初选。制备1×103~1×104 CFU/mL的试验菌悬液,按照《消毒技术规范》(2002年版)中的中和剂初选试验程序开展试验,84消毒液采用0.2%硫代硫酸钠作为中和剂[6],75%乙醇采用2%吐温80作为中和剂,其中活菌培养计数调整为吸取0.1 mL悬液涂布2216E平板培养48 h,活菌计数的同时测定悬液的发光强度,重复3次试验取平均值。
(2)中和剂的鉴定。制备1×108~5×108 CFU/mL试验菌悬液,取2.0 mL试验菌悬液加入2.0 mL有机干扰物质制成含有机干扰物质的菌悬液。按照《消毒技术规范》(2002年版)中的中和剂悬液定量鉴定试验操作程序开展正式的中和剂鉴定试验。其中,活菌培养计数调整为吸取0.1 mL悬液涂布2216E平板培养48 h,重复3次试验取平均值。
1.2.4 发光细菌定量杀灭试验
根据中和剂鉴定结果和费氏弧菌发光强度受中和剂影响较大的情况,发光细菌定量杀灭试验采用明亮发光杆菌作为特定性微生物开展试验。
(1)悬液定量法杀菌试验。用无菌硬水配制84消毒液、乙醇消毒液待测浓度(产品说明书要求的浓度)的1.25倍,取第3代细菌培养物配制浓度为1×108~5×108 CFU/mL的菌悬液。在无菌试管内先加入0.5 mL明亮发光杆菌菌悬液,再加入0.5 mL有机干扰物质BSA,混匀,吸取配制好的消毒液4.0 mL注入其中,迅速混匀消毒作用2 min、5 min、10 min(产品说明书指定的最短作用时间)加相应的中和剂作用 10 min ,以稀释液代替消毒液同步试验作为阳性对照,分别吸取样液做活菌计数[1],同时吸取0.1 mL样液测发光强度与活菌计数方法进行比较,重复3次试验取平均值。
(2)载体制备及测试。制备新鲜的含量为1×108~5×108 CFU/mL的明亮发光杆菌菌悬液,选用滤纸片和金属片为载体,采用滴染法吸取10 µL菌液滴染每片载体,干燥后按活菌培养计数法测每个菌片的回收菌数[1],重复3次试验取平均值。同时,采用大肠埃希氏菌和金黄色葡萄球菌制备菌片做活菌计数与发光菌进行比对。
(3)发光细菌冻干及稳定性检测。按脱脂牛奶和菌悬液1∶1的比例制备明亮发光杆菌西林瓶冻干粉,用3%的NaCL溶液1 mL复苏冻干粉后混匀2 min,在暗室内用肉眼观察是否可见微光[7]。同时,吸取0.1 mL复苏菌液测定发光强度。
(4)涂抹喷雾法杀菌试验。根据明亮发光杆菌不适宜制备载体开展细菌杀灭试验的实际情况,本研究采用新鲜菌悬液涂抹喷雾法和冻干菌直接涂抹喷雾法两种方法开展84消毒液和75%乙醇2种消毒剂的消毒效果评价。取新鲜配制的浓度为1×108~5×108 CFU/mL菌悬液或冻干菌粉复苏液100 μL在无菌平皿内均匀涂抹5 cm×5 cm的区域,选定1个浓度(即产品使用说明书中指定的最低浓度)消毒剂溶液对上述涂抹区域进行均匀喷雾,以稀释液代替消毒液同步试验作为阳性对照;消毒作用2 min、5 min、10 min(产品说明书指定的最短作用时间)后,取无菌棉拭子回收之前涂抹菌液区域立即放入含有相应浓度的5 mL中和剂的试管中,混匀作用10 min后进行活菌培养计数[8],同时分别吸取0.1 mL样液测发光强度,重复3次试验。悬液涂抹时同步采用金黄色葡萄球菌、大肠埃希氏菌和水稻细菌性条斑病菌做比对试验[8-9],与发光细菌法进行比较。
(5)数据处理及分析方法。通过对相对发光度(Relative Light Unit,RLU)进行计算,相对发光度 X =(RLU/RLU0)×100%,RLU为消毒剂作用后的发光度,RLU0 为空白对照(稀释液)发光度。由相对发光度计算微生物杀灭率K(Killing Rate,%),微生物杀灭率K =(X0-X1)/X0×100%,X1为消毒剂作用后的相对发光度,X0为阳性对照(稀释液代替消毒液)发光度。结果与《消毒技术规范》(2002年版)中活菌计数方法杀灭对数值进行比较,其中悬液定量杀灭试验杀灭对数值≥5.00可判定为消毒合格,载体定量杀灭试验杀灭对数值KL(Lilling Log Value)≥3.00可判定消毒合格。分析发光细菌法测定消毒效果与传统培养计数方法的差异。
2 结果与讨论
2.1 培养基的选择
明亮发光杆菌和费氏弧菌通过接种2种商品化的发光菌培养基和一种文献方法培养基,发光强度变化情况如图1—图3所示。结果显示2种发光菌均在2216E液体培养基中有利于生长发光,明亮发光杆菌在接种后22~24 h达到最大发光强度,费氏弧菌在接种后16~18 h达到最大发光强度,而后进入衰亡期。
左: 明亮发光杆菌; 右: 费氏弧菌; 从左至右依次为2216E、发光菌和文献方法培养基
图1 不同培养基培养24 h的发光情况
Fig.1 24 hours luminescence situation of different culture medium
图2 明亮发光杆菌不同培养基中发光强度变化
Fig.2 Luminous intensity changes of Photobacterium phosphoreum in different culture medium
图3 费氏弧菌不同培养基中发光强度变化
Fig.3 Luminous intensity changes of Vibrio fischeri in different culture medium
2.2 发光最佳培养条件
2.2.1 接种量
不同的接种量在同等条件下培养24 h发光强度存在差异(图4),以时间为横坐标、菌体发光强度为纵坐标作图,研究不同接种量对发光菌发光以及生长的影响,结果如图5—图6所示。可以明显看出,在1%~5%的接种量范围内,明亮发光杆菌的发光强度随着接种量的增加而减小,费氏弧菌的发光强度随着接种量的增加而增加,但费氏弧菌在3%~5%接种范围内发光强度变化不大。
2.2.2 培养温度
温度是微生物生长的关键因素之一,本研究所采用的明亮发光杆菌和费氏弧菌均源自海洋,属于低温性微生物[3-5],故本研究选择在15~25℃范围内确定发光菌的最适生长和发光温度。由图7—图9可看出,明亮发光杆菌在18℃时的整体比发光度水平最高,15℃时菌体生长发光水平略低于18℃,在20℃、22℃和25℃较弱;费氏弧菌在15℃、18℃和20℃时的整体比发光度水平较高且变化不大,在22℃、25℃最弱。
图5 接种量对明亮发光杆菌T3发光度的影响
Fig.5 The influence of inoculation amount on the luminous intensity for Photobacterium leucophaeum T3
图6 接种量对费氏弧菌发光度的影响
Fig.6 The influence of inoculation amount on the luminous intensity for Vibrio fischeri
左: 明亮发光杆菌; 右: 费氏弧菌; 从左至右培养温度依次为15℃、18℃、20℃、22℃、25℃
图7 不同温度培养24小时的发光情况
Fig.7 Bioluminescence at different temperatures for 24 hours
2.3 中和剂筛选
2.3.1 中和剂初选结果
对明亮发光杆菌和费氏弧菌分别开展84消毒液和乙醇消毒液的中和剂初选,同时测发光强度,具体数据见表1。结果显示,明亮发光杆菌和费氏弧菌作为特定微生物,其3组平板上长出的菌落数很接近,且均在阳性对照组±50%以内,选用的中和剂可以开展正式的中和剂鉴定试验。但是乙醇消毒液的中和剂2%吐温80对发光菌的发光强度影响较大,尤其对费氏弧菌的发光强度抑制明显,超过了61%。
2.3.2 中和剂鉴定结果
根据2.3.1中和剂初选结果,本研究选用0.2%硫代硫酸钠和2%吐温80分别作为84消毒液和乙醇消毒液的中和剂开展中和剂鉴定试验,具体数据见表2。依据《消毒技术规范》(2002年版)中的中和剂鉴定评价规定,结果显示明亮发光杆菌作为特定微生物,84消毒液和乙醇消毒液的中和剂可判定为合格;费氏弧菌作为特定微生物,其2种消毒剂的第2组菌落数均不符合要求,84消毒液的第3组、第4组、第5组组间菌落数在15%以内,但乙醇消毒液的第3组、第4组、第5组组间菌落数超过了15%,综合评价费氏弧菌的中和剂鉴定结果不合格。
2.4 发光细菌定量杀灭试验
2.4.1 悬液定量法杀菌试验
根据2.3.2中和剂鉴定结果,采用《消毒技术规范》(2002年版)中悬液定量杀菌试验操作程序对明亮发光杆菌开展84消毒液和乙醇消毒液的细菌杀灭试验[1],菌悬液浓度控制在1×108~5×108 CFU/mL之间,在活菌计数的同时测定其发光强度,具体数据见表3。结果显示,84消毒液和75%乙醇消毒液的各次活菌杀灭对数值(KL)均>7.00,可判定为消毒合格;按1.2.4的方法处理发光强度数据,消毒剂作用10 min后的微生物消灭率(K)均>99.9%。
2.4.2 载体制备及测试结果
根据2.4.1试验结果,本研究按照《消毒技术规范》(2002年版)制备了滤纸和金属2种载体的明亮发光杆菌菌片,同时采用金黄色葡萄球菌和大肠埃希氏菌做比对,并开展菌片回收试验,具体结果见表4。结果显示,金黄色葡萄球菌和大肠埃希氏菌活菌回收在 5×105~5×106 CFU/片之间,符合规范要求;而明亮发光杆菌两种载体活菌回收率均在5×105 CFU/片以下,且随着存放时间变长回收率会降低。因此,明亮发光杆菌不适宜制备载体开展细菌杀灭试验。
2.4.3 明亮发光杆菌冻干及稳定性检测
根据2.4.2载体试验结果和明亮发光杆菌可用于快速检测水质毒性的原理[10-12],本研究将明亮发光杆菌制备为西林瓶冻干粉,并对同一批冻干菌粉在1~60 d内测定其1.5 h内发光强度的变化,具体结果见表5。结果显示,明亮发光杆菌冻干粉复苏后1 h内发光强度变化不大,可用于现场测试,且冻干粉在30 d内发光强度较稳定。
2.4.4 涂抹喷雾法杀菌效果评价
(1)菌悬液涂抹喷雾法。对新鲜培养的明亮发光杆菌T3菌悬液开展细菌杀灭试验,并测定其发光强度的变化,同时采用金黄色葡萄球菌、大肠埃希氏菌两种特定性微生物和水稻细菌性条斑病菌同步开展细菌杀灭活菌计数试验,试验结果见表6和表7。结果显示,2种消毒剂作用10 min后明亮发光杆菌的杀灭对数值(KL)均>5.00,其发光强度杀灭率(K)均在99.95%以上,根据活菌计数结果可判断为消毒合格,与金黄色葡萄球菌、大肠埃希氏菌和水稻细菌性条斑病菌消毒效果评价结果一致;3组重复试验中组间活菌计数和发光强度未呈现规律,但组内随着消毒时间延长活菌数量不断下降,其发光强度也不断减弱,活菌杀灭对数值(KL)在5.00~6.00之间的发光强度杀灭率(K)计算平均值为99.9%。因此,发光强度杀灭率(K)≥99.9%时可初步判断活菌杀灭对数值(KL)≥5.00。
(2)冻干菌直接涂抹喷雾法。为方便口岸现场快速评价消毒效果,利用冻干的明亮发光杆菌菌粉现场复苏在1 h内开展定量涂抹喷雾评价消毒效果试验,试验结果见图10和表8。结果显示,2种消毒剂作用10 min后其发光强度较阳性对照急剧下降,活菌杀灭对数值(KL)均>6.00,发光强度杀灭率(K)平均值为99.9%;但从3次重复试验结果显示的发光强度不能直接判断菌落的数量,仅可用同一株菌粉的发光强度变化进行现场消毒效果初筛。
3 结论
发光细菌在不同的培养基、培养温度、接种量等条件下,其发光强度都会受到较大影响,其中和剂鉴定结果表明仅明亮发光杆菌可作为特定性微生物开展消毒效果评价。明亮发光杆菌新鲜菌悬液定量法杀菌试验结果显示84消毒液和75%乙醇消毒液的各次活菌杀灭对数值(KL)均>7.00,符合《消毒技术规范》(2002年版)的要求,其发光强度结果显示消毒剂作用10 min后的微生物消灭率(K)均>99.9%,但测试评价过程中发现明亮发光杆菌对环境温度、试剂盐度、消毒剂种类和中和剂较为敏感,这些因素对发光强度影响较大,目前仅可用于已验证的含氯消毒剂和醇类消毒剂的消毒效果快速初筛,在定量评价方面和对其他类型消毒剂(如季铵盐、过氧化物及醛类等)的适用性方面仍有待进一步验证。
为方便口岸现场及时快速了解消毒效果,鉴于明亮发光杆菌载体活菌回收率低和其快速检测水质毒性的原理,本研究采用明亮发光杆菌菌悬液涂抹喷雾法和冻干粉复苏直接涂抹喷雾法用于现场消毒效果初筛。结果显示,2种方法均可用于快速评价含氯消毒剂和醇类消毒剂的现场消毒效果,发光强度杀灭率(K)≥99.9%时可初步判断消毒合格,其中悬液涂抹喷雾法需要提前培养至可明显目测到发光的新鲜菌液,培养时间较长;而冻干粉复苏直接涂抹喷雾法无需活菌培养可在1 h内完成测试,其冻干菌粉在4℃保存2个月内发光强度仍比较稳定,方便保存和现场应用。与传统的采用致病性微生物开展消毒效果评价方法相比较,该方法具有安全无害、检测迅速、反应灵敏、价格低廉等优点,还可制备成冻干制剂直接测试,应用于各类预防性消毒、卫生处理、动植物疫情除害处理的消毒评价,为含氯消毒剂和醇类消毒剂消毒效果评价提供技术支撑。
参考文献
[1] 中华人民共和国卫生部《消毒技术规范》[S]. 北京: 中国标准出版社, 2002.
[2] 吴淑杭. 发光细菌法快速检测农产品中主要污染物联合毒性技术研究[D]. 上海: 华东师范大学, 2007.
[3] 蒋媛媛, 孟芹, 苏嘉缘, 等. 明亮发光杆菌连续培养条件的优化[J]. 华东理工大学学报(自然科学版), 2016, 42(1): 48-53.
[4] ISO 11348-1, EN Water quality-Determination of the inhibitory effect of water samples on the light emission of Vibrio fischeri (Luminescent bacteria test)-Part 1: Method using freshly prepared bacteria[S]. Switzerland: ISO copyright office, 2007.
[5] 李翔. 费氏弧菌生物发光在水质毒性检测上的应用研究[D]. 广州: 华南理工大学, 2012.
[6] GB 15982—2012 医院消毒卫生标准[S]. 北京: 中国标准出版社, 2012.
[7] ISO 11348-3 Water quality-Determination of the inhibitory effect of water samples on the light emission of Vibrio fischeri (Luminescent bacteria test)-Part 3: Method using freeze-dried bacteria[S]. Switzerland: ISO copyright office, 2007.
[8] GB/T 38504—2020 喷雾消毒效果评价方法[S]. 北京: 中国标准出版社, 2020.
[9] GB 27952—2020 普通物体表面消毒剂通用要求[S].北京: 中国标准出版社, 2020.
[10] GB/T 15441—1995 水质 发光细菌法[S]. 北京: 中国标准出版社, 1995.
[11] SN/T 5103—2019 国境口岸饮用水发光细菌检测方法[S]. 北京: 中国标准出版社, 2019.
[12] 那广水, 张月梅, 陈彤, 等. 发光细菌法评价排污口污水中总有机污染物毒性[J]. 中国环境监测, 2010, 26(5): 61-64.
基金项目:海关总署科研项目(2022HK013)
第一作者:黄迎波(1979—),女,汉族,湖南浏阳人,硕士,高级农艺师,主要从事实验室植物检疫鉴定和微生物检验工作,E-mail: 56704131@qq.com
通信作者:莫瑾(1981—),男,土家族,湖南长沙人,博士,高级工程师,主要从事植物有害生物除害处理及安全控制研究工作,E-mail: 13779735@qq.com
1. 长沙海关技术中心 长沙 410004
1. Changsha Customs Technical Center, Changsha 410004
左: 明亮发光杆菌; 右: 费氏弧菌; 从左至右接种量依次为1%、2%、3%、4%、5%
图4 不同接种量培养24 h的发光情况
Fig.4 Bioluminescence of different inoculation amounts after 24 hours of culture
图8 温度对明亮发光杆菌T3发光强度的影响
Fig.8 The influence of temperature on the luminous intensity for Photobacterium phosphoreum T3
图9 温度对费氏弧菌发光强度的影响
Fig.9 The influence of temperature on the luminous intensity for Vibrio fischeri
费氏弧菌培养温度
表1 中和剂初选试验活菌计数及发光强度
Table 1 The bacterial count and luminescence intensity of the neutralizing preliminary test
中和剂初选分组 | 明亮发光杆菌 | 费氏弧菌 | |||
菌落平均数 (CFU/mL) | 发光强度 (RLU) | 菌落平均数 (CFU/mL) | 发光强度 (RLU) | ||
菌悬液+0.2%硫代硫酸钠 | 37 | 3480 | 80 | 6101 | |
菌悬液+84消毒液中和产物 | 38 | 3232 | 86 | 5593 | |
菌悬液+2%吐温80 | 34 | 2436 | 93 | 1955 | |
菌悬液+75%乙醇中和产物 | 33 | 2077 | 78 | 926 | |
阳性对照 | 36 | 3780 | 82 | 5107 | |
表2 中和剂鉴定试验活菌计数情况
Table 2 The bacterial count of the neutralizing identification test
活菌计数 | 84消毒液 | 75%乙醇 | |||
平均数 (CFU/mL) | 平均数 (CFU/mL) | 平均数 (CFU/mL) | 平均数 (CFU/mL) | ||
第1组: 消毒剂+菌悬液 | 0 | 0 | 0 | 0 | |
第2组: 消毒剂+菌悬液+中和剂 | 70 | 0 | 80 | 0 | |
第3组: 中和剂+菌悬液 | 1.8×107 | 2.4×107 | 1.7×107 | 1.6×107 | |
第4组: 消毒剂+中和剂+菌液 | 2.1×107 | 2.0×107 | 1.5×107 | 1.1×107 | |
第5组: 稀释液+菌悬液 | 1.6×107 | 2.3×107 | 1.6×107 | 2.3×107 | |
第6组: 稀释液+中和剂+培养基 | 0 | 0 | 0 | 0 | |
表3 T3悬液法杀菌活菌计数法和发光菌法效果比较
Table 3 Effects comparison of counting method and luminescent bacteria method of T3 suspension method sterilization
消毒作用时间 | 84消毒液 | 75%乙醇 | |||||||
(CFU/mL) | (KL) | (RLU) | (K, %) | (CFU/mL) | (KL) | 发光强度 (RLU) | (K, %) | ||
阳性对照 (10 min) | 6.7×107 | - | 27540 | - | 5.6×107 | - | 5967 | - | |
2 min | 0 | >7.82 | 10 | 99.96 | 0 | >7.74 | 10 | 99.83 | |
5 min | 0 | >7.82 | 5 | 99.98 | 0 | >7.74 | 6 | 99.89 | |
10 min | 0 | >7.82 | 1 | 99.99 | 0 | >7.74 | 2 | 99.96 | |
注: “-”代表阳性对照使用稀释液代替消毒剂作用,不存在杀灭对数值和杀灭率.
表4 特定微生物载体活菌回收情况
Table 4 Recovery of live bacteria of specific microbial carrier
微生物种类 | 载体种类 | 菌悬液 (CFU/mL) | 菌片第1天 (CFU/片) | 菌片第3天 (CFU/片) | 菌片第7天 (CFU/片) |
明亮发光杆菌T3 | 滤纸 | 4.0×108 | 2.1×104 | 1.0×103 | 117 |
金属 | 1.5×102 | 12 | 0 | ||
金黄色葡萄球菌ATCC 29213 | 滤纸 | 3.1×108 | 1.0×106 | 8.9×105 | 8.7×105 |
金属 | 1.6×107 | 1.2×107 | 1.1×107 | ||
大肠埃希氏菌ATCC 25922 | 滤纸 | 1.5×108 | 6.8×105 | 6.5×105 | 6.6×105 |
金属 | 7.7×106 | 7.1×106 | 7.3×106 |
表5 明亮发光杆菌冻干粉复苏发光情况
Table 5 Recovery of bioluminescence of Photobacterium phosphoreum freeze-dried powder
发光强度 (RLU) | 5 min | 10 min | 15 min | 30 min | 60 min | 90 min |
第1天 | 351324 | 437898 | 487673 | 602389 | 1056738 | 861607 |
第3天 | 333889 | 373608 | 433445 | 540968 | 565601 | 496305 |
第7天 | 1941518 | 1629846 | 1470792 | 1454496 | 1252690 | 1091865 |
第10天 | 1239491 | 1109780 | 941231 | 949171 | 962040 | 764367 |
第15天 | 317127 | 407736 | 414602 | 440405 | 381460 | 319334 |
第30天 | 478505 | 519624 | 531470 | 488169 | 476535 | 417417 |
第60天 | 248154 | 295261 | 302445 | 318954 | 374505 | 331852 |
表6 T3悬液涂抹喷雾杀菌活菌计数法和发光菌法效果比较
Table 6 Effects comparison of colony counting method and luminous bacteria method of T3 suspension smear spray sterilization
消毒作用时间 | 84消毒液 | 75%乙醇 | ||||||||
(CFU/mL) | (KL) | (RLU) | (K, %) | (CFU/mL) | (KL) | (RLU) | (K, %) | |||
重复1 | 阳性对照 | 5.7×106 | - | 3475 | - | 5.6×106 | - | 2077 | - | |
2 min | 1.1×102 | 4.69 | 33 | 99.05 | 1.0×102 | 4.75 | 25 | 98.79 | ||
5 min | 10 | 5.76 | 7 | 99.79 | 0 | >6.75 | 6 | 99.71 | ||
10 min | 0 | >6.76 | 1 | 99.97 | 0 | >6.75 | 1 | 99.95 | ||
重复2 | 阳性对照 | 1.6×107 | - | 52364 | - | 1.0×107 | - | 18374 | - | |
2 min | 3.9×102 | 3.61 | 85 | 99.83 | 1.5×102 | 4.82 | 50 | 99.72 | ||
5 min | 1.6×102 | 5.00 | 41 | 99.92 | 80 | 5.1 | 24 | 99.88 | ||
10 min | 0 | >7.20 | 5 | 99.99 | 10 | 6.00 | 8 | 99.95 | ||
重复3 | 阳性对照 | 5.9×107 | - | 179024 | - | 1.5×107 | - | 83036 | - | |
2 min | 7.8×102 | 4.88 | 162 | 99.90 | 3.1×102 | 4.69 | 105 | 99.87 | ||
5 min | 3.5×102 | 5.23 | 95 | 99.94 | 1.2×102 | 5.10 | 80 | 99.90 | ||
10 min | 70 | 5.92 | 41 | 99.97 | 40 | 5.58 | 31 | 99.96 | ||
注: “-”代表阳性对照使用稀释液代替消毒剂作用,不存在杀灭对数值和杀灭率.
表7 其他微生物菌悬液同步定量涂抹喷雾法杀菌试验结果
Table 7 The test results of suspension synchronous quantitative coating spray method sterilizationof other microbial
微生物 | 84消毒液 | 75%乙醇 | ||||
菌落平均数 (CFU/mL) | 杀灭对数值 (KL) | 菌落平均数 (CFU/mL) | 杀灭对数值 (KL) | |||
金黄色葡萄球菌ATCC 6538 | 阳性对照 | 3.3×108 | - | 3.1×108 | - | |
消毒10 min | 0 | >8.52 | 0 | >8.49 | ||
大肠埃希氏菌ATCC 8739 | 阳性对照 | 6.0×108 | - | 5.4×108 | - | |
消毒10 min | 0 | >8.78 | 0 | >8.73 | ||
水稻细菌性条斑病菌NCPPB 1511 | 阳性对照 | 3.8×106 | - | 1.2×106 | - | |
消毒10 min | 1 | 6.58 | 0 | >6.08 | ||
注: “-”代表阳性对照使用稀释液代替消毒剂作用,不存在杀灭对数值和杀灭率.
图10 T3冻干粉复苏直接涂抹喷雾杀菌试验活菌计数情况
Fig.10 Live bacteria count situation of T3 freeze-dried powder recovery direct spray sterilization test
表8 T3冻干菌复苏涂抹喷雾杀菌活菌计数法和发光菌法比较
Table 8 Comparison of counting method and luminescent bacteria method of T3 freeze-dried bacteria recovery
smear spray sterilization
消毒作用时间 | 84消毒液 | 75%乙醇 | ||||||||
(CFU/mL) | (KL) | (RLU) | (K, %) | (CFU/mL) | (KL) | (RLU) | (K, %) | |||
冻干粉1 | 阳性对照 | 8.7×106 | - | 18846 | - | 8.4×106 | - | 4539 | - | |
10 min | 0 | >6.94 | 2 | 99.94 | 0 | >6.92 | 3 | 99.85 | ||
冻干粉2 | 阳性对照 | 2.0×107 | - | 38671 | - | 2.4×107 | - | 12633 | - | |
10 min | 0 | >7.30 | 5 | 99.99 | 0 | >7.38 | 7 | 99.94 | ||
冻干粉3 | 阳性对照 | 6.8×106 | - | 1051 | - | 6.2×106 | - | 564 | - | |
10 min | 0 | >6.83 | 1 | 99.90 | 0 | >6.79 | 1 | 99.82 | ||
注: “-”代表阳性对照使用稀释液代替消毒剂作用,不存在杀灭对数值和杀灭率.